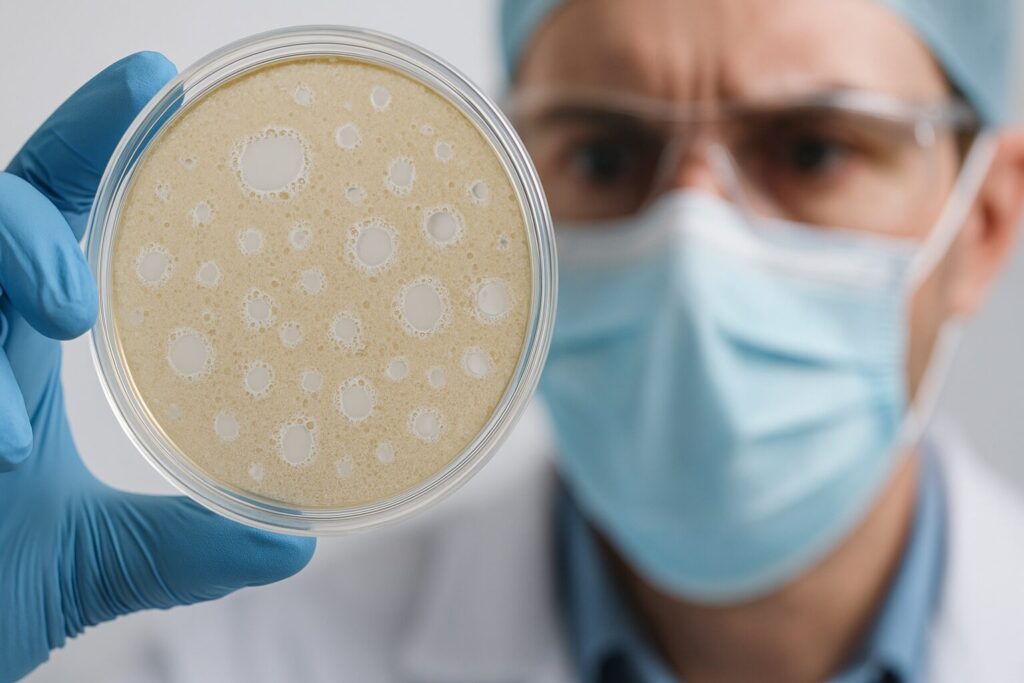

Health experts say the Nipah virus poses limited global risk for now. Concerns grow over potential lab manipulation increasing its pandemic threat.
Posts tagged as “pandemic”
The system never recovered from the pandemic but for a few years it relied on government pandemic money to keep it going. By 2023, that money was starting to run out and services had to be cut.
by Jon Rappoport The global medical community has been asserting that “a pandemic is being caused by a virus, SARS-Cov-2.” But what if the virus…
By Noah Time for a Fact Check! I saw this video going viral on Twitter and for good reason….it claims to show the Moderna CEO…
By STEPHEN GREEN “When I was Vice President, things were kinda bad during the pandemic,” is not a thing former Veep Mike Pence said…
By Brenda Baletti, Ph.D. The Biden White House on Tuesday announced a new 50-country partnership to “combat future pandemics” by identifying and responding to infectious disease outbreaks,…
By Jacob M. Thompson Scientists in the mainstream media are once again sounding the alarm on this relatively quiet spread of a strain of avian…
by Noah People all over the world never want to hear the word “vaccine” again after the pandemic debacle. Yet, with new mRNA biotechnology ready…
By Jacob M. Thompson The simulation also predicted the collapse of Ukraine by 2023, and anticipated the radical changes worldwide to be the “new normal.”…
By Jacob M. Thompson Of the many things artificial intelligence has allowed for and transformed, one of them is communicating with those that have passed…
By Andi Joe Biden has officially announced where his 2024 headquarters will be located. The Biden campaign has announced they will run Biden’s 2024 presidential campaign…
By Planet Today The Trudeau regime was the first WEF-controlled government to outlaw independent media, meaning Canadians who share articles or posts online that are…
NEWS PROVIDED BY SK bioscience SEOUL, South Korea, Oct. 25, 2022 /PRNewswire/ — SK bioscience, a global innovative vaccine and biotech company committed to promoting human…
By Molly Weisner Neither federal employees and nor contractors will be required to be vaccinated against COVID-19 come May 11, according to the White House Monday. The Biden administration said it…
By WND Staff ‘We don’t know when’ Three highly influential world leaders are assuring the public that there will be another pandemic. COVID-19, of course,…